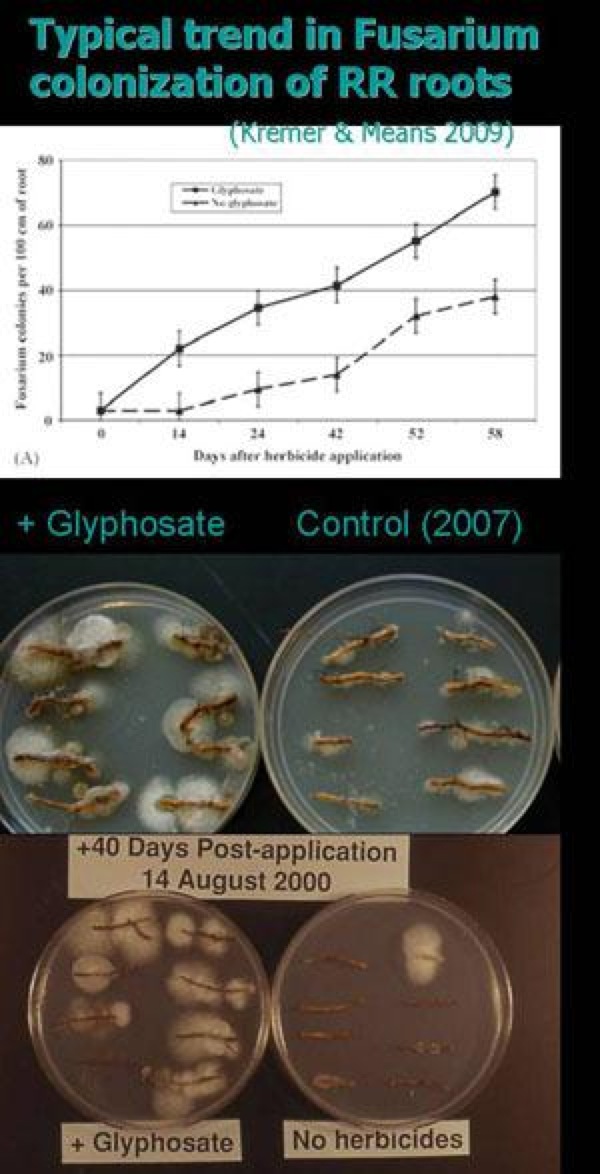
Pasted Graphic 7

Chuck Noble

To: Alfalfa Growers and Seed Dealers
1. Roundup Ready© genetically engineered (GE) alfalfa should not be grown (attachments follow).
2. Conventional alfalfa is being contaminated by GE alfalfa through pollen drift from GE alfalfa fields. The pollen gene is carried by bees and crosses with conventional alfalfa genes and contaminates the seed with the crossed bred GE seed. There are other sources of contamination such as harvesting and seed handling.
3. Neighbors with conventional alfalfa fields near genetically engineered alfalfa fields are being contaminated and harmed.
4. Monsanto and the United States Department of Agriculture are being sued in Federal courts concerning GE alfalfa seed patents. Monsanto has sued and are suing others concerning patent infringement and other issues such as using contaminated conventional seed.
5. Super weeds that are resistant to Roundup© are rapidly increasing.
6. Data (see Jeffrey Smith attachment) shows uptake of soil nutrients to plants are reduced due to Roundup©. Also, Roundup© causes plant diseases.
7. Data (see Jeffrey Smith attachment) shows alfalfa forage nutrients are reduced when Roundup© is present.
8. All conventional alfalfa will be contaminated by Roundup Ready© alfalfa over time unless we stop Monsanto’s attempt to monopolize all the seed.
9. We must not grow Roundup Ready© alfalfa.
Attachments: USDA Agr Sec Vilsack 12.19.2010 Jeffrey Smith Roundup Triggers Diseases 1.4.2011 (12 pages) USDA ARS Greene Prelim Report (partial) 12.07.2011 (6 pages) Mercola Worse than DDT 01.15.2012 WSJ Letter to Editor Green Revolution & GE Myths 02.07.2012 NY Federal Court Hearing 12.06.2012 U.S. Congress re GE 12.30.2012 WA DC Appeals Court Hearing 01.23.2013
Chuck Noble, Alfalfa and Seed Grower
Lowell Denbesten, Seed Dealer
Pat Trask, Alfalfa and Seed Grower
Perry Guptill, Alfalfa and Seed Grower
May 9, 2013
———————————————————————
To: USDA Secretary Tom Vilsack
FROM: Chuck Noble SUBJ: Alfalfa Coexistence
Conventional and GE alfalfa coexistence is not possible or practical; some reasons:
1. The USDA should realize that not all crops can coexist nor should all crops be genetically engineered.
2. A monopoly is growing in the seed industry which is threatening to destroy independent seed producers.
3. Technologically, perennial crops: alfalfa and grasses, should not be genetically engineered because they cannot be kept in the fence, human inserted genes must be controlled.
4. 230,000 negative comments were received on the 2009 Draft EIS.
5. Approximately 100,000 acres of GE alfalfa were planted in two years out of over 20 million acres of conventional alfalfa. Most of the GE acres have been taken out.
6. GE alfalfa takes 20% more seed to establish the same stand as conventional alfalfa.
7. The GE gene does not add nutrition and the herbicide on the plants do not have nutrition.
8. Many of us use Roundup to kill alfalfa stands in crop rotations. GE alfalfa will be a weed not easily killed in other crops being grown.
9. GE alfalfa seed is becoming costly to keep out of conventional seed lots. Accurate tests and hygiene, clean combines, cleaners, and isolated fields are all issues. Since the Magna Carta, 1215 AD, we have the right to grow our crops without being trespassed by man-caused genes.
10. To allow GE alfalfa to be grown for a small number of people who want to plant into their weed patches is poor reasoning. The majority of growers timely suppress weeds and use crop rotation management wisely.
11. Coexistence of GE alfalfa is not possible without wrecking the conventional alfalfa and seed industry and causing further monopoly.
12. Up to half of USA seed production comes from alfalfa second growth such as I grow.
13. GE alfalfa will add costs to all producers and consumers. The benefit goes to the monopoly patent holder as we get further and further contaminated.
14. Genetically engineered effects are very difficult to back out of a perennial crop such as alfalfa and must not be allowed.
I have worked hard on this issue for 5 years. I was at the USDA-APHIS meeting in Colorado in Oct., 2007, representing the 100,000’s of growers against the contaminating trends of Monsanto’s GE alfalfa. I was raised on a Western South Dakota farm, have a science education and raise alfalfa hay and grass for dairy buyers and other buyers. I sell alfalfa seed from second growth alfalfa and our operation also supports honey bee production, which too is adversely affected by GE alfalfa.
Chuck Noble
December 19, 2010
———————————————————————
Jeffrey Smith, The world’s leading consumer advocate promoting healthier, non- GMO choices
Monsanto’s Roundup Triggers Over 40 Plant Diseases and Endangers Human and Animal Health
The following article reveals the devastating and unprecedented impact that Monsanto’s Roundup herbicide is having on the health of our soil, plants, animals, and human population. On top of this perfect storm, the USDA now wants to approve Roundup Ready alfalfa, which will exacerbate this calamity. Please tell USDA Secretary Vilsack not to approve Monsanto’s alfalfa today.
While visiting a seed corn dealer’s demonstration plots in Iowa last fall, Dr. Don Huber walked passed a soybean field and noticed a distinct line separating severely diseased yellowing soybeans on the right from healthy green plants on the left (see photo). The yellow section was suffering from Sudden Death Syndrome (SDS), a serious plant disease that ravaged the Midwest in 2009 and ’10, driving down yields and profits. Something had caused that area of soybeans to be highly susceptible and Don had a good idea what it was.
Don Huber spent 35 years as a plant pathologist at Purdue University and knows a lot about what causes green plants to turn yellow and die prematurely. He asked the seed dealer why the SDS was so severe in the one area of the field and not the other. “Did you plant something there last year that wasn’t planted in the rest of the field?” he asked. Sure enough, precisely where the severe SDS was, the dealer had grown alfalfa, which he later killed off at the end of the season by spraying a glyphosate-based herbicide (such as Roundup). The healthy part of the field, on the other hand, had been planted to sweet corn and hadn’t received glyphosate.

The diseased field on the right had glyphosate applied the previous season. Photo by Don Huber
This was yet another confirmation that Roundup was triggering SDS. In many fields, the evidence is even more obvious. The disease was most severe at the ends of rows where the herbicide applicator looped back to make another pass (see photo). That’s where extra Roundup was applied.
Don’s a scientist; it takes more than a few photos for him to draw conclusions. But Don’s got more―lots more. For over 20 years, Don studied Roundup’s active ingredient glyphosate. He’s one of the world’s experts. And he can rattle off study after study that eliminate any doubt that glyphosate is contributing not only to the huge increase in SDS, but to the outbreak of numerous other diseases. (See selected reading list.)


Sudden Death Syndrome is more severe at the ends of rows, where Roundup dose is strongest. Photo by Amy Bandy.
Roundup: The perfect storm for plant disease
More than 30% of all herbicides sprayed anywhere contain glyphosate―the world’s bestselling weed killer. It was patented by Monsanto for use in their Roundup brand, which became more popular when they introduced “Roundup Ready” crops starting in 1996. These genetically modified (GM) plants, which now include soy, corn, cotton, canola, and sugar beets, have inserted genetic material from viruses and bacteria that allows the crops to withstand applications of normally deadly Roundup.
(Monsanto requires farmers who buy Roundup Ready seeds to only use the company’s Roundup brand of glyphosate. This has extended the company’s grip on the glyphosate market, even after its patent expired in 2000.)
The herbicide doesn’t destroy plants directly. It rather cooks up a unique perfect storm of conditions that revs up disease-causing organisms in the soil, and at the same time wipes out plant defenses against those diseases. The mechanisms are well-documented but rarely cited.
1. The glyphosate molecule grabs vital nutrients and doesn’t let them go. This process is called chelation and was actually the original property for which glyphosate was patented in 1964. It was only 10 years later that it was patented as an herbicide. When applied to crops, it deprives them of vital minerals necessary for healthy plant function―especially for resisting serious soil-borne diseases. The importance of minerals for protecting against disease is well established. In fact, mineral availability was the single most important measurement used by several famous plant breeders to identify disease-resistant varieties.
2. Glyphosate annihilates beneficial soil organisms, such as Pseudomonas Bacillus that live around the roots. Since they facilitate the uptake of plant nutrients and suppress disease-causing organisms, their untimely deaths means the plant gets even weaker and the pathogens even stronger.
3. The herbicide can interfere with photosynthesis, reduce water use efficiency, lower lignin , damage and shorten root systems, cause plants to release important sugars, and change soil pH―all of which can negatively affect crop health.
4. Glyphosate itself is slightly toxic to plants. It also breaks down slowly in soil to form another chemical called AMPA (aminomethylphosphonic acid) which is also toxic. But even the combined toxic effects of glyphosate and AMPA are not sufficient on their own to kill plants. It has been demonstrated numerous times since 1984.

Glyphosate with sterile soil (A) only stunts plant growth. In normal soil (B), pathogens kill the plant. Control (C) shows normal growth.
1. That when glyphosate is applied in sterile soil, the plant may be slightly stunted, but it isn’t killed (see photo).
2. The actual assassins, according to Purdue weed scientists and others, are severe disease-causing organisms present in almost all soils. Glyphosate dramatically promotes these, which in turn overrun the weakened crops with deadly infections.
“This is the herbicidal mode of action of glyphosate,” says Don. “It increases susceptibility to disease, suppresses natural disease controls such as beneficial organisms, and promotes virulence of soil-borne pathogens at the same time.” In fact, he points out that “If you apply certain fungicides to weeds, it destroys the herbicidal activity of glyphosate!”
By weakening plants and promoting disease, glyphosate opens the door for lots problems in the field. According to Don, “There are more than 40 diseases of crop plants that are reported to increase with the use of glyphosate, and that number keeps growing as people recognize the association between glyphosate and disease.”
Roundup promotes human and animal toxins
Some of the fungi promoted by glyphosate produce dangerous toxins that can end up in food and feed. Sudden Death Syndrome, for example, is caused by the Fusarium . USDA scientist Robert Kremer found a 500% increase in Fusarium infection of Roundup Ready soybeans when glyphosate is applied (see photos and chart). Corn, wheat, and many other plants can also suffer from serious Fusarium-based .
But Fusarium’s is not limited to plants. According to a report by the UN Food and Agriculture Organization, toxins from Fusarium various types of food crops have been associated with disease outbreaks throughout history. They’ve “been linked to the plague epidemics” of medieval Europe, “large-scale human toxicosis in Eastern Europe,” oesophageal cancer in southern Africa and parts of China, joint diseases in Asia and southern Africa, and a blood disorder in Russia. Fusarium have also been shown to cause animal diseases and induce infertility.
As Roundup use rises, plant disease skyrockets
When Roundup Ready crops were introduced in 1996, Monsanto boldly claimed that herbicide use would drop as a result. It did―slightly―for three years. But over the next 10 years, it grew considerably. Total herbicide use in the US jumped by a whopping 383 million pounds in the 13 years after GMOs came on the scene. The greatest contributor is Roundup.
Over time, many types of weeds that would once keel over with just a tiny dose of Roundup now require heavier and heavier applications. Some are nearly invincible. In reality, these super-weeds are resistant not to the glyphosate itself, but to the soil-borne pathogens that normally do the killing in Roundup sprayed fields.
Having hundreds of thousands of acres infested with weeds that resist plant disease and weed killer has been devastating to many US farmers, whose first response is to pour on more and more Roundup. Its use is now accelerating. Nearly half of the huge 13-year increase in herbicide use took place in just the last 2 years. This has serious .
As US farmers drench more than 135 million acres of Roundup Ready crops with Roundup, plant diseases are enjoying an unprecedented explosion across America’s most productive crop lands. Don rattles off a lengthy list of diseases that were once under effective management and control, but are now creating severe hardship. (The list includes SDS and Corynespora root rot of soybeans, citrus variegated chlorosis (CVC), Fusarium wilt of cotton, Verticillium wilt of potato, take-all root, crown, and stem blight of cereals, Fusarium root and crown rot, Fusarium head blight, Pythium root rot and damping off, Goss’ wilt of corn, and many more.)
In Brazil, the new “Mad Soy Disease” is ravaging huge tracts of soybean acreage. Although scientists have not yet determined its cause, Don points out that various symptoms resemble a rice disease (bakanae) which is caused by Fusarium.
Corn dies young
In recent years, corn plants and entire fields in the Midwest have been dying earlier and earlier due to various diseases. Seasoned and observant farmers say they’re never seen anything like it.
“A decade ago, corn plants remained green and healthy well into September,” says Bob Streit, an agronomist in Iowa. “But over the last three years, diseases have turned the plants yellow, then brown, about 8 to 10 days earlier each season. In 2010, yellowing started around July 7th and yield losses were devastating for many growers.”
Bob and other crop experts believe that the increased use of glyphosate is the primary contributor to this disease trend. It has already reduced corn yields significantly. “If the corn dies much earlier,” says Bob, “it might collapse the corn harvest in the US, and threaten the food chain that it supports.”
A question of bugs
In addition to promoting plant diseases, which is well-established, spraying Roundup might also promote insects. That’s because many bugs seek sick plants. Scientists point out that healthy plants produce nutrients in a form that many insects cannot assimilate. Thus, farmers around the world report less insect problems among high quality, nutrient-dense crops. Weaker plants, on the other hand, create insect smorgasbords. This suggests that plants ravaged with diseases promoted by glyphosate may also attract more insects, which in turn will increase the use of toxic pesticides. More study is needed to confirm this.
Roundup persists in the environment
Monsanto used to boast that Roundup is biodegradable, claiming that it breaks down quickly in the soil. But courts in the US and Europe disagreed and found them guilty of false advertising. In fact, Monsanto’s own test data revealed that only 2% of the product broke down after 28 days.
Whether glyphosate degrades in weeks, months, or years varies widely due to factors in the soil, including pH, clay , types of minerals, residues from Roundup Ready crops, and the presence of the specialized enzymes needed to break down the herbicide molecule. In some conditions, glyphosate can grab hold of soil nutrients and remain stable for long periods. One study showed that it took up to 22 years for glyphosate to degrade only half its volume! So much for trusting Monsanto’s product claims.
Glyphosate can attack from above and below. It can drift over from a neighbors farm and wreak havoc. And it can even be released from dying weeds, travel through the soil, and then be taken up by healthy crops.

The amount of glyphosate that can cause damage is tiny. European scientists demonstrated that less than half an ounce per acre inhibits the ability of plants to take up and transport essential micronutrients (see chart).
As a result, more and more farmers are finding that crops planted in years after is applied suffer from weakened defenses and increased soil-borne diseases. The situation is getting worse for many reasons.
1. The glyphosate concentration in the soil builds up season after season with each subsequent application.
2. Glyphosate can also accumulate for 6-8 years inside perennial plants like alfalfa, which get sprayed over and over.
3. (See photos below)
4. Glyphosate residues in the soil that become bound and immobilized can be reactivated by the application of phosphate fertilizers or through other methods. Potato growers in the West and Midwest, for example, have experienced severe losses from glyphosate that has been reactivated.
5. Glyphosate can find its way onto farmland accidentally, through drifting spray, in contaminated water, and even through chicken manure!
Imagine the shock of farmers who spread chicken manure in their fields to add nutrients, but instead found that the glyphosate in the manure tied up nutrients in the soil, promoted plant disease, and killed off weeds or crops. Test results of the manure showed glyphosate/AMPA concentrations at a whopping 0.36-0.75 parts per million (ppm). The normal rate of glyphosate is about 0.5 ppm/acre.

Wheat affected after 10 years of glyphosate field applications.
Manure from other animals may also be spreading the herbicide, since US livestock consume copious amounts of glyphosate―which accumulates in corn kernels and soybeans. If it isn’t in livestock manure (or urine), that may be even worse. If glyphosate is not exiting the animal, it must be accumulating with every meal, ending up in our meat and possibly milk.
Add this threat to the already high glyphosate residues inside our own diets due to corn and soybeans, and we have yet another serious problem threatening our health. Glyphosate has been linked to sterility, hormone disruption, abnormal and lower sperm counts, miscarriages, placental cell death, birth defects, and cancer, to name a few. (See resource list on glyphosate health effects.)
Nutrient loss in humans and animals
The same nutrients that glyphosate chelates and deprives plants are also vital for human and animal health. These include iron, zinc, copper, manganese, magnesium, calcium, boron, and others. Deficiencies of these elements in our diets, alone or in combination, are known to interfere with vital enzyme systems and cause a long list of disorders and diseases.
Alzheimer’s, for example, is linked with reduced copper and magnesium. Don Huber points out that this disease has jumped 9000% since 1990.
Manganese, zinc, and copper are also vital for proper functioning of the SOD (superoxide dismustase) cycle. This is key for stemming inflammation and is an important component in detoxifying unwanted chemical compounds in humans and animals.
Glyphosate-induced mineral deficiencies can easily go unidentified and untreated. Even when laboratory tests are done, they can sometimes detect mineral levels, but miss the fact that glyphosate has already rendered them unusable.
Glyphosate can tie up minerals for years and years, essentially removing them from the pool of nutrients available for plants, animals, and humans. If we combine the more than 135 million pounds of glyphosate-based herbicides applied in the US in 2010 with total applications over the past 30 years, we may have already millions of pounds of nutrients from our food supply.
This loss is something we simply can’t afford. We’re already suffering from progressive nutrient deprivation even without Roundup. In a UK study, for example, they found between 16-76% less nutrients in 1991, compared to levels in the same foods in 1940.
Livestock disease and mineral deficiency
Roundup Ready crops dominate US livestock feed. Soy and corn are most prevalent―93% of US soy and nearly 70% of corn are Roundup Ready. Animals are also fed derivatives of the other three Roundup Ready crops: canola, sugar beets, and cottonseed. Nutrient loss from glyphosate can therefore be severe.
This is especially true for manganese (Mn), which is not only chelated by glyphosate, but also reduced in Roundup Ready plants (see photo). One veterinarian finds low manganese in every liver he measures. Another vet sent the liver of a stillborn calf out for testing. The lab report stated: No Detectible Levels of Manganese―in of the fact that the mineral was in adequate concentrations in his region. When that vet started adding manganese to the feed of a herd, disease rates dropped from a staggering 20% to less than 0.5%.

Veterinarians who started their practice after GMOs were introduced in 1996 might assume that many chronic or acute animal disorders are common and to be expected. But several older vets have stated flat out that animals have gotten much sicker since GMOs came on the scene. And when they switch livestock from GMO to non-GMO feed, the improvement in health is dramatic. Unfortunately, no one is tracking this, nor is anyone looking at the impacts of consuming milk and meat from GM-fed animals.
Alfalfa madness, brought to you by Monsanto and the USDA
As we continue to drench our fields with Roundup, the perfect storm gets bigger and bigger. Don asks the sobering question: “How much of the hundreds of millions of pounds of glyphosate that have been applied to our most productive farm soils over the past 30 years is still available to damage subsequent crops through its effects on nutrient availability, increased disease, or reduced nutrient of our food and feed?”
Instead of taking urgent steps to protect our land and food, the USDA just made plans to make things worse. In December they released their Environmental Impact Statement (EIS) on Roundup Ready alfalfa, which Monsanto hopes to reintroduce to the market.
Alfalfa is the fourth largest crop in the US, grown on 22 million acres. It is used primarily as a high protein source to feed dairy cattle and other ruminant animals. At present, weeds are not a big deal for alfalfa. Only 7% of alfalfa acreage is ever sprayed with an herbicide of any kind. If Roundup Ready alfalfa is approved, however, herbicide use would jump to unprecedented levels and the weed killer of choice would of course be Roundup.
Even without the application of glyphosate, the nutritional quality of Roundup Ready alfalfa will be less, since Roundup Ready crops, by their nature, have reduced mineral. When glyphosate is applied, nutrient quality suffers even more (see chart).

The chance that Roundup would increase soil-borne diseases in alfalfa fields is a near certainty. In fact, Alfalfa may suffer more other Roundup Ready crops. As a perennial, it can accumulate Roundup year after year. It is a deep-rooted plant, and glyphosate leaches into sub soils. And “Fusarium is a very serious pathogen of alfalfa,” says Don. “So too are Phytophthora Pythium,” of which are promoted by glyphosate. “Why would you even consider jeopardizing the productivity and nutrient quality of the third most valuable crop in the US?” he asks in frustration, “especially since we have no way of removing the gene once it is spread throughout the alfalfa gene pool.”
It’s already spreading. Monsanto had marketed Roundup Ready alfalfa for a year, until a federal court declared its approval to be illegal in 2007. They demanded that the USDA produce an EIS in order to account for possible environmental damage. But even with the seeds taken off the market, the RR alfalfa that had already been planted has been contaminating non-GMO varieties. Cal/West Seeds, for example, discovered that more than 12% of their seed lots tested positive for contamination in 2009, up from 3% in 2008.
In their EIS, the USDA does that genetically modified alfalfa can contaminate organic and non-GMO alfalfa, and that this could create economic hardship. They are even considering the unprecedented step of placing restrictions on RR alfalfa seed fields, requiring isolation distances. Experience suggests that this will slow down, but not eliminate GMO contamination. Furthermore, studies confirm that genes do from GM crops into soil and soil organisms, and can jump into fungus through cuts on the surface of GM plants. But the EIS does not adequately address these threats and their implications.
Instead, the USDA largely marches lock-step with the biotech industry and turns a blind eye to the widespread harm that Roundup is already . If they decide to approve Monsanto’s alfalfa, the USDA may ultimately be blamed for a catastrophe of epic proportions.
———————————————————————






———————————————————————
Worse Than DDT: When you Eat This… It Ends Up Lingering in Your Gut
By Dr. Mercola, January 15, 2012
His complete Interview can be found on his website (www.mercola.com):
http://articles.mercola.com/sites/articles/archive/2012/01/15/dr-don-huber-interview-part-2.aspx
The Story At-A-Glance
• The major danger of genetically engineered foods may be related to the increased use of glyphosate, the active ingredient in Monsanto’s weed killer Glyphosate, which is the most common weed killer in the US and just happens to be more toxic than DDT. Roundup, can accumulate and persist in the soil for years, where it kills off beneficial microbes and stimulates virulence of pathogens
• Since organically-farmed fields are not doused with glyphosate, organic fields still contain beneficial soil bacteria that actually hinder in and on the food from multiplying out of control. This may be yet another reason why organic foods are less prone to be contaminated with disease-causing pathogens than conventionally grown foods
• When applied to crops, glyphosate becomes systemic throughout the plant, so it cannot be washed off. And once you eat this crop, the glyphosate ends up in your gut where it can decimate your beneficial bacteria. This can wreak havoc with your health as 80 percent of your immune system resides in your gut and is dependent a healthy ratio of good and bad bacteria
• Glyphosate is a strong chelator, meaning it immobilizes critical micronutrients, rendering them unavailable to the plant. As a result, the nutritional efficiency of genetically engineered (GE) plants is profoundly compromised. such as iron, manganese and zinc can be reduced by as much as 80-90 percent in GE plants
———————————————————————
Letter to the Editor February 7, 2011
The Green Revolution and Genetic Engineering Myths
The green revolution has been going on for thousands of years or eons according to the natural law of the survival of the fittest.
In response to “Let’s Restart the Green Revolution” by Holman W. Jenkins Jr., February 2, 2011, Wall Street Journal, the main factors of agriculture production are: weather, management, crop inputs, economics and markets.
For several decades changes have occurred such as availability of commercial fertilizer derived from cheap oil but not so recently, no till farming methods, and large machinery. The perception of green may be due to heavy use of fertilizer. Alfalfa forage crops have also increased the green appearance. In addition, alfalfa is used to grow our own nitrogen as well as suppressing weeds. Alfalfa out- competes weeds and is a good neighbor for bees, sources of pollen, nectar and pollinizing for seed reproduction.
Genetically engineered plant varieties have been introduced in the last decade. I do not believe GE crops have much to do with green. Myself and other experts have not been able to find any data to support the premise that GE increases production. However, the perception is that GE varieties are easier to grow compared to conventional varieties. The GE varieties versus plant diseases and insect pests are evolving in a more complex unwise manner.
In the last decades, many biology educated people have been moving towards GE activities without codes of conduct and ethics. As a result, harmful consequences are occurring.
Some important issues, both business and technical, follow:
1. Highly flawed or invalid GE patents
2. Regulatory approvals, lack of testing and labeling
3. Property rights of growers and their gene pool varieties
4. Genetic diversity of conventional crops
5. GE contamination of plants and seed
6. Super weed evolution
7. Safety tests and toxic effects of chemicals and genes
8. Monopoly control of seed supply and ability of growers to sell their own seed
This recent GE activity can be compared to the 19th century when millions of people starved in the European potato famine. This famine resulted because only three genetic varieties of potatoes were grown and all were susceptible to potato blight. Genetic diversity is an issue as noted above.
We are in a primitive state in solving the above issues in relation to the GE varieties and the monopoly control consequences.
Uncontrollable GE varieties need to be restricted. Any monopoly control of the growers’ plant genetics by GE contamination is unacceptable. Boundaries and limits of GE varieties must be established to insure the safety, health and protect the property rights of the growers land.
Currently, the USDA deregulates GE varieties without sufficient limits and controls. A consequence is conventional varieties will become extinct due to GE contamination and cross-breeding. Further, monopoly control of the genetics will occur over time and this would be unacceptable.
Chuck Noble grew up on a South Dakota farm, has a science education and owns a farm. He raises conventional alfalfa forage and seed and wheat for seed and flour. He sells hay for milk and dry dairy cows, beef cattle, sheep, horses, buffalo, goats, llamas and even guineas.
Chuck Noble
———————————————————————
Opposing GE Patents Notes from the Big City, Week of January 31, 2012
The main purpose was to attend the oral hearing in Southern District Federal Court in New York City concerning the lawsuit against Monsanto GE patents. I have provided a written declaration in August 2011 and our attorney requested my presence. I was mentioned as was Bryce Stevens as representative of people harmed by GE patent. The hearing lasted 11⁄2 hours and the small courtroom had approximately 75 people with some standing.
There was an assembly outside of the courthouse; some twelve of us spoke including myself, a number of reporters, freelance writers and a Steve Colbert representative interviewed us. Interviews were held Tuesday, Wednesday and Thursday. A number of small conferences were held.
Impacts on reporters and public:
1. I have dirt under my fingernails
2. Independent and private funded tests need to be done to measure GE seed contamination and the presence of herbicide and other toxins in the GE crops used for feed and food. Also, the presence of these toxins needs to be measured in food, meat, milk and eggs. Some data exists that identifies a quantity of glyphosate in meat, milk and eggs. We need to verify and get more data.
3. We have a fundamental property right not to be trespassed by GE contamination clear back to the Magna Carta, 1215 AD. San Francisco Judge Breyer and several Supreme Court judges acknowledge this sense of fairness and justice.
4. Cattlemen used to free range in the 1800’s. They tried to run over people who had fenced, deeded property. They did not prevail. Monsanto is trying to free range the GE genes and they will not prevail.
5. The Genie can be put back in the bottle. Only 100,000 acres of GE alfalfa out of 23 million acres were planted. Most growers (6) who planted GE in my county got rid of it after I explained what they signed in the Monsanto technology agreement and that they would harm their neighbors with gene flow.
6. Why is Monsanto doing GE seed? I believe it is greed, corporate power, control (monopoly) and management egos.
7. Discuss GE with your grocery retailers. Example: They are trying to GE peppers. No one wants them except buyers who want growers on contracts that they can control.
8. The genetic diversity of our gene pools is at stake. The European and Scandinavian potato famines of 1850-1900 killed millions of people because only four potato varieties were grown and all were susceptible to potato blight. We do not need to repeat this experiment.
9. We must not let companies monopolize our gene pools and seed.
10. It appears that Monsanto wants to go back to pre-Magna Carta when the serfs grew the crops and the kings let them keep only enough to survive. They took the rest and the serfs could not own land or crops.
I have worked hard on this GE issue for 6 years. I was at the USDA-APHIS meeting in Colorado in Oct., 2007, representing the 100,000’s of growers against the contaminating trends of Monsanto’s GE alfalfa.
I grew up on a South Dakota farm, have a science degree and own a farm. I sell hay for milk and dry dairy cows, beef cattle, sheep, horses, buffalo, goats, llamas and even guineas. My hay and seed market is all over the U.S. and export.
February 6, 2012
Chuck Noble